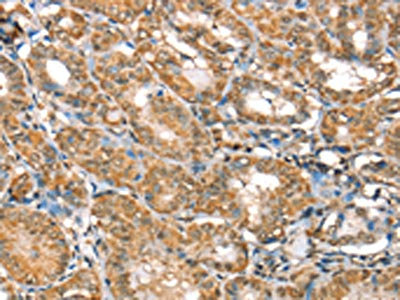

RBM5 Antibody
-
中文名稱:RBM5兔多克隆抗體
-
貨號:CSB-PA085970
-
規格:¥1100
-
圖片:
-
The image on the left is immunohistochemistry of paraffin-embedded Human ovarian cancer tissue using CSB-PA085970(RBM5 Antibody) at dilution 1/30, on the right is treated with fusion protein. (Original magnification: ×200)
-
The image on the left is immunohistochemistry of paraffin-embedded Human thyroid cancer tissue using CSB-PA085970(RBM5 Antibody) at dilution 1/30, on the right is treated with fusion protein. (Original magnification: ×200)
-
Gel: 6%SDS-PAGE, Lysate: 40 μg, Lane 1-6: 823 cells, A549 cells, K562 cells, 293T cells, hepg2 cells, huvec cells, Primary antibody: CSB-PA085970(RBM5 Antibody) at dilution 1/450, Secondary antibody: Goat anti rabbit IgG at 1/8000 dilution, Exposure time: 10 seconds
-
-
其他:
產品詳情
-
Uniprot No.:
-
基因名:RBM5
-
別名:FLJ39876 antibody; G15 antibody; H37 antibody; LUCA 15 antibody; LUCA15 antibody; Protein G15 antibody; Putative tumor suppressor LUCA15 antibody; RBM 5 antibody; Rbm5 antibody; RBM5_HUMAN antibody; Renal carcinoma antigen NY REN 9 antibody; Renal carcinoma antigen NY-REN-9 antibody; RMB 5 antibody; RMB5 antibody; RNA binding motif protein 5 antibody; RNA binding protein 5 antibody; RNA-binding motif protein 5 antibody; RNA-binding protein 5 antibody; Tumor suppressor LUCA15 antibody
-
宿主:Rabbit
-
反應種屬:Human,Mouse,Rat
-
免疫原:Fusion protein of Human RBM5
-
免疫原種屬:Homo sapiens (Human)
-
標記方式:Non-conjugated
-
抗體亞型:IgG
-
純化方式:Antigen affinity purification
-
濃度:It differs from different batches. Please contact us to confirm it.
-
保存緩沖液:-20°C, pH7.4 PBS, 0.05% NaN3, 40% Glycerol
-
產品提供形式:Liquid
-
應用范圍:ELISA,WB,IHC
-
推薦稀釋比:
Application Recommended Dilution ELISA 1:2000-1:5000 WB 1:500-1:2000 IHC 1:25-1:100 -
Protocols:
-
儲存條件:Upon receipt, store at -20°C or -80°C. Avoid repeated freeze.
-
貨期:Basically, we can dispatch the products out in 1-3 working days after receiving your orders. Delivery time maybe differs from different purchasing way or location, please kindly consult your local distributors for specific delivery time.
-
用途:For Research Use Only. Not for use in diagnostic or therapeutic procedures.
相關產品
靶點詳情
-
功能:Component of the spliceosome A complex. Regulates alternative splicing of a number of mRNAs. May modulate splice site pairing after recruitment of the U1 and U2 snRNPs to the 5' and 3' splice sites of the intron. May both positively and negatively regulate apoptosis by regulating the alternative splicing of several genes involved in this process, including FAS and CASP2/caspase-2. In the case of FAS, promotes exclusion of exon 6 thereby producing a soluble form of FAS that inhibits apoptosis. In the case of CASP2/caspase-2, promotes exclusion of exon 9 thereby producing a catalytically active form of CASP2/Caspase-2 that induces apoptosis.
-
基因功能參考文獻:
- RNA binding motif protein 10 (RBM10) negatively regulates its own mRNA and protein expression and that of RNA binding motif protein 5 (RBM5) by promoting alternative splicing-coupled nonsense-mediated mRNA decay (AS-NMD). PMID: 28586478
- results provide evidence that RBM10 expression, in RBM5-null tumors, may contribute to tumor growth and metastasis. Measurement of both RBM10 and RBM5 expression in clinical samples may therefore hold prognostic and/or potentially predictive value PMID: 28662214
- the mechanism of action of RBM5-AS1 in the WNT pathway via physical interactions with beta-catenin, helping organize transcriptional complexes that sustain colon cancer-initiating cells function. PMID: 27520449
- Low RBM5 expression was significantly associated with gliomas. PMID: 28061901
- RNA-binding motif 5 silencing reduced the messenger RNA and protein expression of the p53 target gene p21. Our results suggest that RNA-binding motif 5 downregulation is involved in gastric cancer progression and that RNA-binding motif 5 behaves as a tumor suppressor gene in gastric cancer PMID: 28347247
- Results show that RBM5 is downregulated in smoke induced tumor; its overexpression inhibits tumor growth through cell cycle arrest and induction of apoptosis suggesting the importance of RBM5 in the pathogenesis of smoking-related cancer. PMID: 26782095
- ICG-001 had no apparent effect on the RBM5 levels. PMID: 25738917
- RBM5 knockdown in human neuronal cells decreases caspase activation by staurosporine. PMID: 25586139
- Loss of RBM5 expression is associated with lung adenocarcinoma. PMID: 23721095
- expression of RBM5 protein was significantly decreased in cancerous prostatic tissues compared to the normal tissues PMID: 23158838
- RBM5 can inhibit the growth of lung cancer cells and induce apoptosis both in vitro and in vivo. PMID: 22866867
- Expression of RBM5 mRNA and protein was negatively correlated with expression of EGFR and KRAS mRNA and protein in NSCLC tissues. PMID: 22537942
- RBM5 promotes exon 4 skipping of AID pre-mRNA by competing with the binding of U2AF65 to the polypyrimidine tract. PMID: 23017209
- RBM5 may serve as a biomarker with the ability to predict a response to cisplatin PMID: 22609235
- The results suggest that RBM5 expression is not directly regulated by EGFR in non-smoker related lung adenocarinomas. PMID: 22882865
- NMR data analysis of RBM5 RRM2 reveals several features of protein-RNA interfaces. The most striking observation is the presence of two preferred target RNA sequences, the sequences [5'-(CUCUUC)-3'] and [5'-(GAGAAG)-3']. PMID: 22839758
- Data suggest that G-patch domain of RBM5 is indispensable for its ability to interact with DHX15; RBM5 stimulates helicase activity of DHX15 in a G-patch domain-dependent manner. PMID: 22569250
- alters expression of genes involved in metastasis PMID: 20338664
- p53 transactivation is involved in the antiproliferative activity of the putative tumor suppressor RBM5. PMID: 20309933
- Over-expression of the splice variant LUCA15 shortened the cell cycle and inhibited CD95-mediated apoptosis in CEM-C7 T-cells. PMID: 12581154
- LUCA-15/RMB5 sensitises Jurkat cells to apoptosis initiated by anti-Fas antibody, TNF-alpha, or TRAIL. PMID: 15192330
- Results provide the first evidence of an apoptotic modulatory role for LUCA-15 in MCF-7 breast carcinoma cell line, which is a non-T cell line. PMID: 15338470
- Results suggest that LUCA-15 plays a central role in regulating cell fate consistent with its tumor suppressor activity. PMID: 16546166
- H37 was transfected into A549 non-small cell lung cancer cells. A549/H37 cells show significant growth inhibition compared with the vector controls by in vitro and in vivo cell proliferation assays. PMID: 16585163
- Results suggest that reversible phosphorylation of RBM5 is a mechanism capable of regulating RBM5 participation in modulating apoptosis, and perhaps tumour suppression. PMID: 16927403
- analysis of Hedgehog modulator properties after functional coupling of Smoothened to G15 PMID: 16945339
- specific allele types at C1138T and C2185T single nucleotide polymorphisms positions are correlated with different histological subtypes of non-small cell lung cancer PMID: 17606309
- In breast tumour tissue, chimeric expression was associated with elevated levels of RBM5 mRNA, and increased tumour size. PMID: 17908320
- suggest some of the possible, further- alternative means of the H37/RMB5 gene expression loss in tumor, including defects in transcription and post-transcriptional/translational modifications as well as mechanisms related to haploinsufficiency PMID: 18038152
- RBM5 binds to casp-2 pre-mRNA at a U/C-rich sequence immediately upstream of the previously identified In100 splicing repressor element PMID: 18840686
- RBM5 inhibits the transition between prespliceosomal complexes assembled around exon 6 to mature spliceosomes assembled on the flanking introns and promotes sequence-specific pairing of the distal splice sites. PMID: 18851835
- LUST is a novel, functional, non-coding RNA that plays a role in determining the apoptotic fate of a cell by regulating the expression of RBM5 splice variants. PMID: 19559772
顯示更多
收起更多
-
亞細胞定位:Nucleus.
-
蛋白家族:RBM5/RBM10 family
-
組織特異性:Isoform 5 is widely expressed in normal tissues and is expressed at increased levels in T-leukemic cell lines.
-
數據庫鏈接:
Most popular with customers
-
-
YWHAB Recombinant Monoclonal Antibody
Applications: ELISA, WB, IHC, IF, FC
Species Reactivity: Human, Mouse, Rat
-
Phospho-YAP1 (S127) Recombinant Monoclonal Antibody
Applications: ELISA, WB, IHC
Species Reactivity: Human
-
-
-
-
-